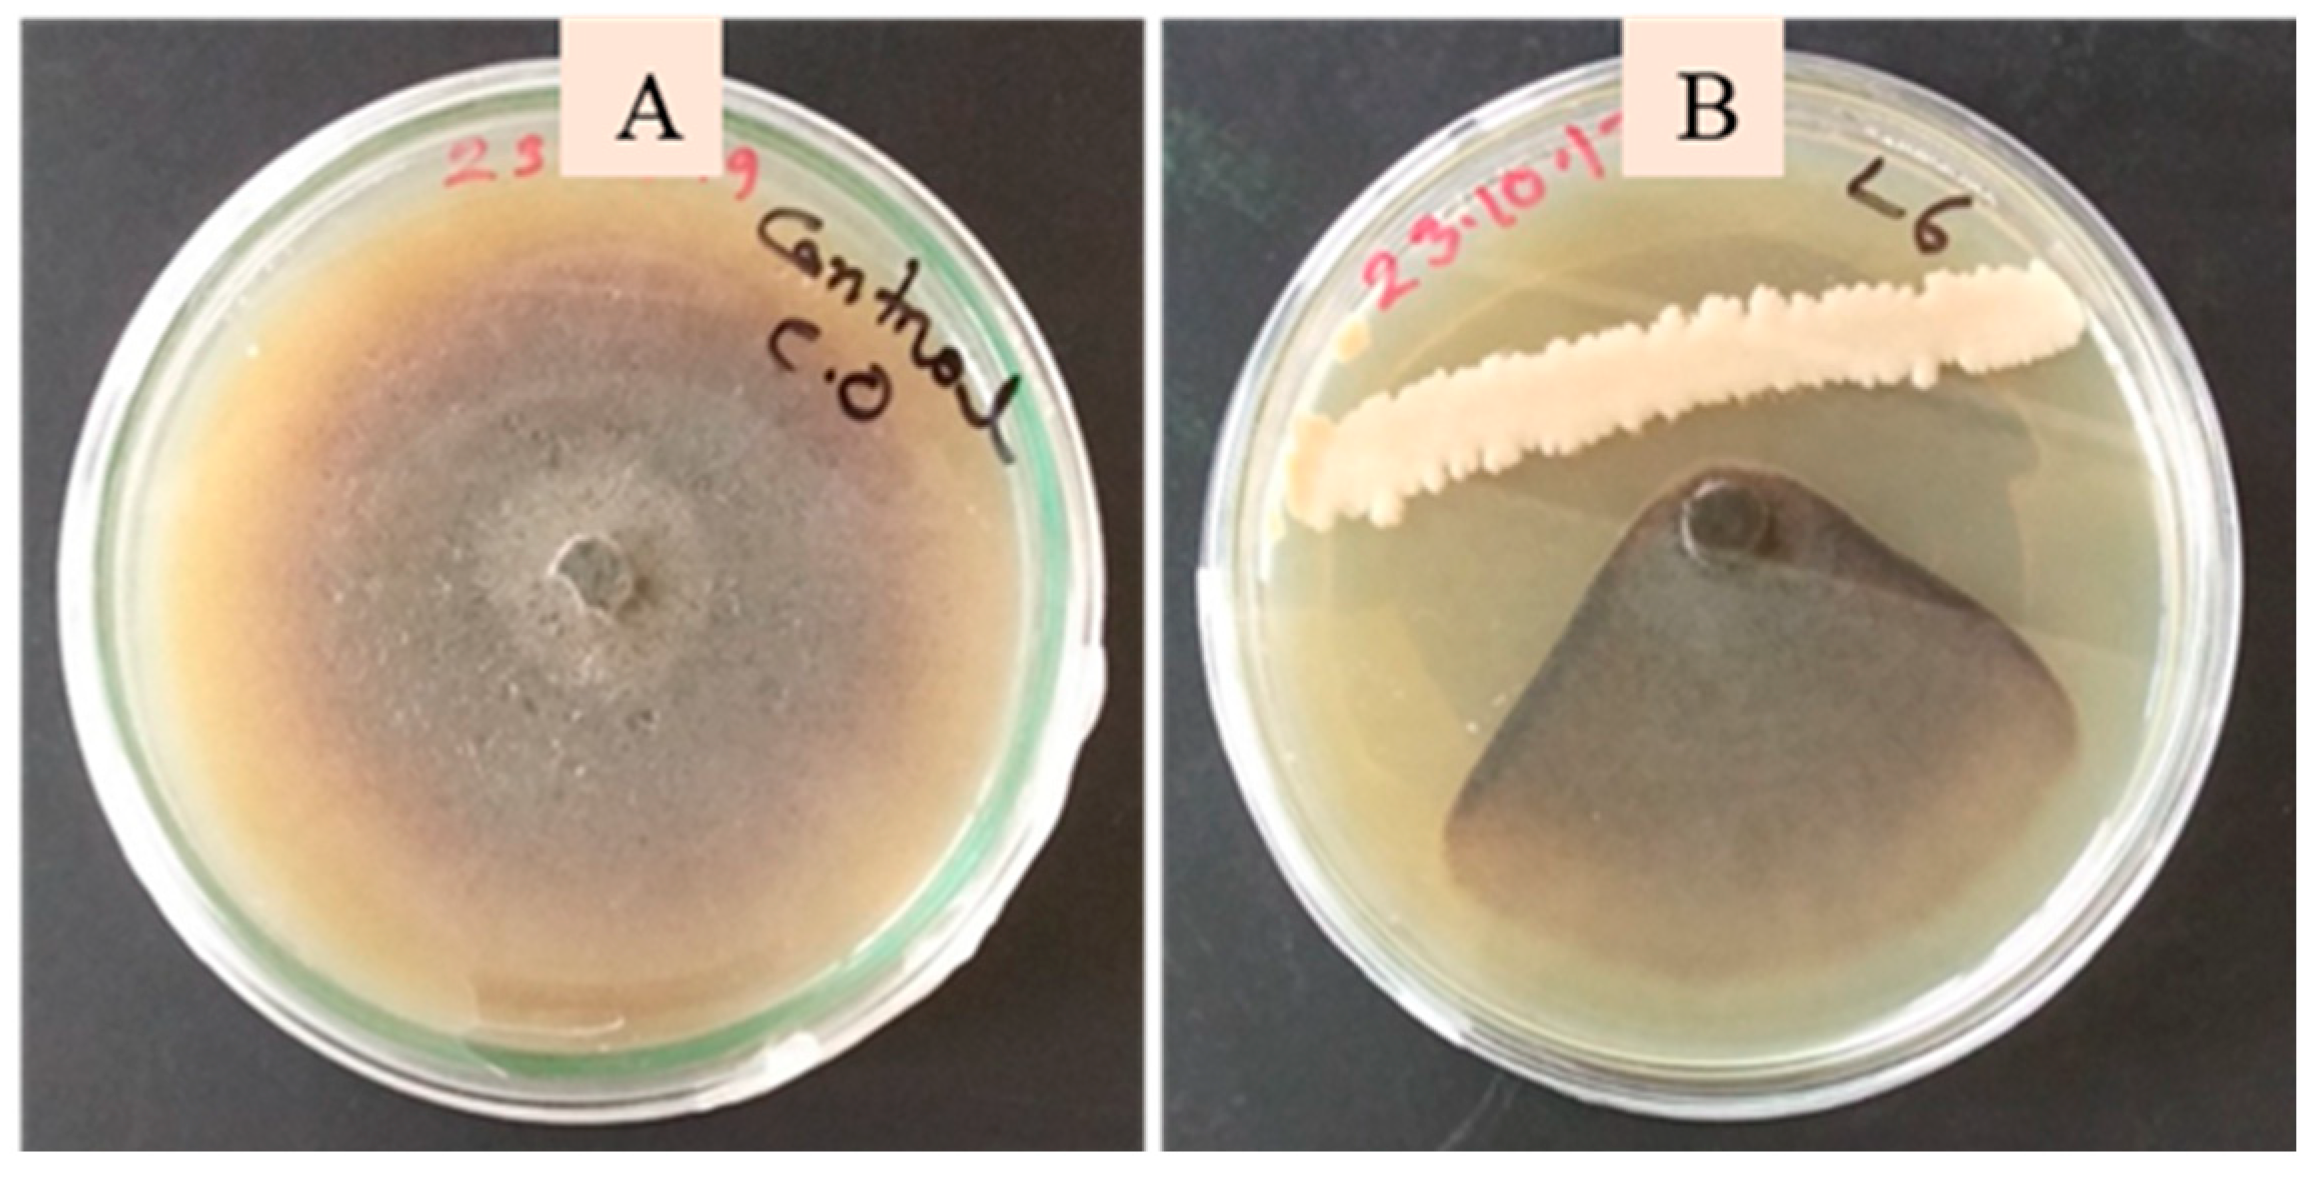

Phyllosphere Antagonistic Bacteria Induce Growth Promotion and Effective Anthracnose Control in Cucumber
Abstract
1. Introduction
2. Materials and Methods
2.1. Sampling and Isolation of Phyllosphere Bacteria from Cucumber
2.2. Host Plant and Pathogen
2.3. Screening of the Bacterial Isolates Against C. orbiculare Using a Dual Plate Confrontation Assay
2.4. Morphological, Biochemical, and Molecular Characterization of the Selected Bacterial Isolates
2.5. Qualitative Screening of Hydrolytic Enzyme Activity
2.6. Biochemical and Metabolite Production Assays
2.7. Motility Test
2.8. In Vitro Biofilm Formation
2.9. Preparation of Bacterial Inoculum and Cucumber Seed Treatment
2.10. Effect of Phyllobacterial Treatment on the Growth of Cucumber Plants in Soil with and Without Organic Manure
2.11. Effect of Phyllobacteria on the Suppression of Anthracnose in Cucumber Plants in Soil with and Without Organic Manure
2.12. Bacterial Colonization Assay
2.13. Statistical Analysis
3. Results
3.1. Isolation and Selection of Bacterial Isolates
3.2. Morphological, Biochemical, and Molecular Characterization of Phyllobacterial Isolates
3.3. Plant-Growth-Promoting Traits of the Phyllobacterial Strains
3.4. Biocontrol Traits of the Phyllobacterial Strains
3.5. Effect of Phytobacterial Treatments on Cucumber Growth Parameters
3.6. Effect of Phyllobacterial Treatment on the Growth of Cucumber Plants in Organically Manured Soil
3.7. Effect of Phyllobacteria on Suppression of C. orbiculare in Cucumber Plants in Soils with and Without Organic Manure
3.8. Leaf and Root Colonization by Phyllobacteria
4. Discussion
5. Conclusions
Author Contributions
Funding
Data Availability Statement
Acknowledgments
Conflicts of Interest
References
- Zheng, L.; Gu, C.; Cao, J.; Li, S.-M.; Wang, G.; Luo, Y.-M.; Guo, J.-H. Selecting Bacterial Antagonists for Cucurbit Downy Mildew and Developing an Effective Application Method. Plant Dis. 2018, 102, 628–639. [Google Scholar] [CrossRef]
- Wang, S.; Heal, K.V.; Zhang, Q.; Yu, Y.; Tigabu, M.; Huang, S.; Zhou, C. Soil microbial community, dissolved organic matter and nutrient cycling interactions change along an elevation gradient in subtropical China. J. Environ. Manag. 2023, 345, 118793. [Google Scholar] [CrossRef]
- Mukherjee, P.K.; Nema, N.K.; Maity, N.; Sarkar, B.K. Phytochemical and therapeutic potential of cucumber. Fitoterapia 2013, 84, 227–236. [Google Scholar] [CrossRef]
- Ríos, J.L. Effects of Triterpenes on the Immune System. J. Ethnopharmacol. 2010, 128, 1–14. [Google Scholar] [CrossRef]
- Katiyar, S.; Saify, K.; Singh, S.K.; Rai, M. Botanical study of skin lightening agents. Int. J. Pharmacogn. 2014, 1, 534–544. [Google Scholar]
- Suryawanshi, R.K.; Patil, C.D.; Borase, H.P.; Narkhede, C.P.; Stevenson, A.; Hallsworth, J.E.; Patil, S.V. Towards an understanding of bacterial metabolites prodigiosin and violacein and their potential for use in commercial sunscreens. Int. J. Cosmet. Sci. 2015, 37, 98–107. [Google Scholar] [CrossRef]
- Akhtar, N.; Mehmood, A.; Khan, B.A.; Mahmood, T.; Khan, H.M.S.; Saeed, T. Exploring Cucumber Extract for Skin Rejuvenation. Afr. J. Biotechnol. 2011, 10, 1206–1216. [Google Scholar]
- Hossain, M.M.; Sultana, F.; Miyazawa, M.; Hyakumachi, M. The Plant Growth-promoting Fungus Penicillium spp. GP15-1 Enhances Growth and Confers Protection against Damping-off and Anthracnose in the Cucumber. J. Oleo Sci. 2014, 63, 391–400. [Google Scholar] [CrossRef] [PubMed]
- Hausbeck, M.K.; Lamour, K.H. Phytophthora capsici on Vegetable Crops: Research Progress and Management Challenges. Plant Dis. 2004, 88, 1292–1303. [Google Scholar] [CrossRef]
- Chai, C.H.; Hong, C.-F.; Huang, J.-W. Identification and Characterization of a Multifunctional Biocontrol Agent, Streptomyces griseorubiginosus LJS06, Against Cucumber Anthracnose. Front. Microbiol. 2022, 13, 923276. [Google Scholar] [CrossRef] [PubMed]
- Ko, E.J.; Shin, Y.H.; Hyun, H.N.; Song, H.S.; Hong, J.K.; Jeun, Y.C. Bio-Sulfur Pre-Treatment Suppresses Anthracnose on Cucumber Leaves Inoculated with Colletotrichum orbiculare. Mycobiology 2019, 47, 308–318. [Google Scholar] [CrossRef]
- Devarajan, A.K.; Muthukrishanan, G.; Truu, J.; Truu, M.; Ostonen, I.; Subramanian Kizhaeral, S.; Panneerselvam, P.; Gopalasubramanian, S.K. The Foliar Application of Rice Phyllosphere Bacteria induces Drought-Stress Tolerance in Oryza sativa (L.). Plants 2021, 10, 387. [Google Scholar] [CrossRef]
- Rubiales, D.; Fondevilla, S.; Chen, W.; Gentzbittel, L.; Higgins, T.J.V.; Castillejo, M.A.; Singh, K.B.; Rispail, N. Achievements and Challenges in Legume Breeding for Pest and Disease Resistance. Crit. Rev. Plant Sci. 2014, 34, 195–236. [Google Scholar] [CrossRef]
- Yue, C.; Du, C.; Wang, X.; Tan, Y.; Liu, X.; Fan, H. Powdery mildew-induced changes in phyllosphere microbial community dynamics of cucumber. FEMS Microbiol. Ecol. 2024, 100, fiae050. [Google Scholar] [CrossRef]
- Ni, L.; Punja, Z.K. Management of Fungal Diseases on Cucumber (Cucumis sativus L.) and Tomato (Solanum lycopersicum L.) Crops in Greenhouses Using Bacillus Subtilis. In Bacilli and Agrobiotechnology: Phytostimulation and Biocontrol. Bacilli in Climate Resilient Agriculture and Bioprospecting; Springer: Cham, Switzerland, 2019. [Google Scholar]
- Patil, N.; Raghu, S.; Mohanty, L.; Jeevan, B.; Basana-Gowda, G.; Adak, T.; Annamalai, M.; Rath, P.C.; Sengottayan, S.-N.; Govindharaj, G.-P. Rhizosphere Bacteria Isolated from Medicinal Plants Improve Rice Growth and Induce Systemic Resistance in Host Against Pathogenic Fungus. J. Plant Growth Regul. 2024, 43, 770–786. [Google Scholar] [CrossRef]
- Jain, A.; Chatterjee, A.; Das, S. Synergistic consortium of beneficial microorganisms in rice rhizosphere promotes host defense to blight-causing Xanthomonas oryzae pv. oryzae. Planta 2020, 252, 106. [Google Scholar] [CrossRef]
- Yang, F.; Jiang, H.; Chang, G.; Liang, S.; Ma, K.; Cai, Y.; Tian, B.; Shi, X. Effects of Rhizosphere Microbial Communities on Cucumber Fusarium wilt Disease Suppression. Microorganisms 2023, 11, 1576. [Google Scholar] [CrossRef]
- Wang, C.; Pan, G.; Lu, X.; Qi, W. Phosphorus solubilizing microorganisms: Potential promoters of agricultural and environmental engineering. Front. Bioeng. Biotechnol. 2023, 11, 1181078. [Google Scholar] [CrossRef]
- Rangel, L.I.; Leveau, J.H.J. Applied microbiology of the phyllosphere. Appl. Microbiol. Biotechnol. 2024, 108, 211. [Google Scholar] [CrossRef]
- Compant, S.; Duffy, B.; Nowak, J.; ClémEnt, C.; Barka, E.A. Use of Plant Growth-Promoting Bacteria for Biocontrol of Plant Diseases: Principles, Mechanisms of Action, and Future Prospects. Appl. Environ. Microbiol. 2005, 71, 4951–4959. [Google Scholar] [CrossRef]
- De Mandal, S.; Jeon, J. Phyllosphere Microbiome in Plant Health and Disease. Plants 2023, 12, 3481. [Google Scholar] [CrossRef]
- Bonaterra, A.; Cabrefiga, J.; Camps, J.; Montesinos, E. Increasing survival and efficacy of a bacterial biocontrol agent of fire blight of rosaceous plants by means of osmoadaptation. FEMS Microbiol. Ecol. 2007, 61, 185–195. [Google Scholar] [CrossRef][Green Version]
- Vorholt, J.A. Microbial life in the phyllosphere. Nat. Rev. Microbiol. 2012, 10, 828–840. [Google Scholar] [CrossRef] [PubMed]
- Bulgarelli, D.; Schlaeppi, K.; Spaepen, S.; Van Themaat, E.V.L.; Schulze-Lefert, P. Structure and Functions of the Bacterial Mi-crobiota of Plants. Annu. Rev. Plant Biol. 2013, 64, 807–838. [Google Scholar] [CrossRef] [PubMed]
- Kembel, S.W.; O’cOnnor, T.K.; Arnold, H.K.; Hubbell, S.P.; Wright, S.J.; Green, J.L. Relationships between phyllosphere bacterial communities and plant functional traits in a neotropical forest. Proc. Natl. Acad. Sci. USA 2014, 111, 13715–13720. [Google Scholar] [CrossRef]
- Hari, S.B.; Briste, P.S.; Sumi, A.A.; Mosharaf, M.K.; Paul, S.I.; Masum, M.M.I.; Jannat, R. Endophytic bacteria isolated from medicinal plants induce plant growth promotion and southern blight disease suppression in tomato. J. Plant Pathol. 2022, 105, 197–210. [Google Scholar] [CrossRef]
- Kemal, S.; Koricha, A.D.; Parise, A. The Art, Microbial Quality, Safety, and Physicochemical Characteristics of Jikita: A Traditional Ethiopian Fermented Beverage. Int. J. Food Sci. 2024, 2024, 6698831. [Google Scholar] [CrossRef]
- Islam, S.; Akanda, A.M.; Prova, A.; Islam, M.T.; Hossain, M.M. Isolation and Identification of Plant Growth Promoting Rhizobacteria from Cucumber Rhizosphere and Their Effect on Plant Growth Promotion and Disease Suppression. Front. Microbiol. 2016, 6, 1360. [Google Scholar] [CrossRef]
- Setyaningsih, P.P.; Ningsih, F.; Rachmania, M.K.; Syafitri, W.A.; Sari, D.C.A.F.; Yabe, S.; Yokota, A.; Oetari, A.; Sjamsuridzal, W. Cellulolytic enzyme-producing thermophilic Actinobacteria isolated from the soil of Cisolok Geysers, West Java, Indonesia. Biodiversitas J. Biol. Divers. 2019, 20, 3134–3141. [Google Scholar] [CrossRef]
- Yahia, M.S.; Mohamed, M.K.; Othman, M.S.; Mostafa, D.N.; Gomaa, M.M.; Fahmy, M.A.; Shaaban, R.H.; Kamel, A.M.; Abdelhai, M.F.; Radwan, W.H.; et al. Isolation and identification of antibiotic producing Pseudomonas fluorescens NBRC-14160 from Delta Soil in Egypt. Arab. Univ. J. Agric. Sci. 2020, 28, 797–808. [Google Scholar] [CrossRef]
- Perwendha, R.; Oetari, A.; Sjamsuridzal, W. Skimmed Milk-Degrading Ability of Rhizopus Azygosporus UICC 539 at Various Temperatures. AIP Conf. Proc. 2020, 2242, 050006. [Google Scholar] [CrossRef]
- Cappuccino, J.G. Natalie Sherman Microbiology: A Laboratory Manual, 10th ed.; References—Scientific Research Publishing; Pearson Education Limited: London, UK, 2013; Available online: https://www.scirp.org/reference/referencespapers?referenceid=2887944 (accessed on 16 August 2025).
- Hossain, M.M.; Sultana, F. Methods for the Characterization of Plant-Growth Promoting Rhizobacteria. Methods Mol. Biol. 2018, 1734, 307–328. [Google Scholar] [CrossRef]
- El Habil-Addas, F.; Aarab, S.; Rfaki, A.; Laglaoui, A.; Bakkali, M.; Arakrak, A. Screening of Phosphate Solubilizing Bacterial Isolates for Improving Growth of Wheat. Available online: https://www.researchgate.net/publication/320988789_Screening_of_phosphate_solubilizing_bacterial_isolates_for_improving_growth_of_wheat (accessed on 16 August 2025).
- MacWilliams, M.P. Indole Test Protocol; American Society for Microbiology for Microbiology: Washington, DC, USA, 2009. [Google Scholar]
- Sameer, K.; Sobanbabu, G.; Sabarinathan, K.G.; Parthiban, V.K.; Ramamoorthy, V. Evaluation of phyllosphere antagonistic bacteria on the management of Fusarium ear rot of maize caused by Fusarium verticillioides. J. Biol. Control. 2018, 32, 257–263. [Google Scholar] [CrossRef]
- Janakiev, T.; Dimkić, I.; Bojić, S.; Fira, D.; Stanković, S.; Berić, T. Bacterial communities of plum phyllosphere and characterization of indigenous antagonistic Bacillus thuringiensis R3/3 isolate. J. Appl. Microbiol. 2019, 128, 528–543. [Google Scholar] [CrossRef]
- Shao, Z.; Schenk, P.M.; Dart, P. Phyllosphere bacterial strains Rhizobium b1 and Bacillus subtilis b2 control tomato leaf diseases caused by Pseudomonas syringae pv. tomato and Alternaria solani. J. Appl. Microbiol. 2023, 134, lxad139. [Google Scholar] [CrossRef]
- Sobanbabu, G.; Oviya, R.; Meena, B.; Vijayasamundeeswari, A.; Shanmugaiah, V.; Ramamoorthy, V. Evaluation of phyllosphere bacterial biocontrol agents for the suppression of rice foliar diseases. J. Phytopathol. 2024, 172, E3300. [Google Scholar] [CrossRef]
- Wiraswati, S.M.; Nawangsih, A.A.; Rusmana, I.; Wahyudi, A.T. Rice phyllosphere bacteria producing antifungal compounds as biological control agents of blast disease. Biodiversitas J. Biol. Divers. 2020, 21, 1223–1278. [Google Scholar] [CrossRef]
- Liu, M.; Zhang, Q.; Jin, R.; Zhao, P.; Zhu, X.; Wang, J.; Yu, Y.; Tang, Z. The Role of IAA in Regulating Root Architecture of Sweetpotato (Ipomoea batatas [L.] Lam) in Response to Potassium Deficiency Stress. Plants 2023, 12, 1779. [Google Scholar] [CrossRef] [PubMed]
- Eivy, F.Z.; Rubayet, T.; Sarkar, U.; Hossain, M. Suppression of Bipolaris Leaf Blotch and Improvement of Wheat Growth by Plant Growth Promoting Rhizobacteria Bacilli. Online J. Biol. Sci. 2024, 24, 412–426. [Google Scholar] [CrossRef]
- Hossain, M.M. Utilization of Stenotrophomonas koreensis and Bacillus amyloliquefaciens for Improving Growth, Reducing Nitrogen Fertilization and Controlling Bipolaris sorokiniana in Wheat. Caraka Tani: J. Sustain. Agric. 2024, 39, 81–93. [Google Scholar] [CrossRef]
- Timofeeva, A.M.; Galyamova, M.R.; Sedykh, S.E. Plant Growth-Promoting Soil Bacteria: Nitrogen Fixation, Phosphate Solubilization, Siderophore Production, and Other Biological Activities. Plants 2023, 12, 4074. [Google Scholar] [CrossRef]
- Su, F.; Zhao, B.; Dhondt-Cordelier, S.; Vaillant-Gaveau, N. Plant-Growth-Promoting Rhizobacteria Modulate Carbohydrate Metabolism in Connection with Host Plant Defense Mechanism. Int. J. Mol. Sci. 2024, 25, 1465. [Google Scholar] [CrossRef]
- Nazari, M.; Kordrostami, M.; Ghasemi-Soloklui, A.A.; Eaton-Rye, J.J.; Pashkovskiy, P.; Kuznetsov, V.; Allakhverdiev, S.I. Enhancing Photosynthesis and Plant Productivity through Genetic Modification. Cells 2024, 13, 1319. [Google Scholar] [CrossRef]
- Al Methyeb, M.; Ruppel, S.; Eichler-Löbermann, B.; Vassilev, N. The Combined Applications of Microbial Inoculants and Organic Fertilizer Improve Plant Growth under Unfavorable Soil Conditions. Microorganisms 2023, 11, 1721. [Google Scholar] [CrossRef]
- Chowdhury, S.K.; Roy, N.; Banerjee, M.; Basnett, D. Plant growth promotion and antifungal activities of the mango phyllosphere bacterial consortium for the management of Fusarium wilt disease in pea (Pisum sativum L.). Plant Sci. Today 2023, 10, 220–234. [Google Scholar] [CrossRef]
- Valdez, A.F.; de Souza, T.N.; Bonilla, J.J.A.; Zamith-Miranda, D.; Piffer, A.C.; Araujo, G.R.S.; Guimarães, A.J.; Frases, S.; Pereira, A.K.; Fill, T.P.; et al. Traversing the Cell Wall: The Chitinolytic Activity of Histoplasma capsulatum Extracellular Vesicles Facilitates Their Release. J. Fungi 2023, 9, 1052. [Google Scholar] [CrossRef]
- Khan, N.; Martínez-Hidalgo, P.; Ice, T.A.; Maymon, M.; Humm, E.A.; Nejat, N.; Sanders, E.R.; Kaplan, D.; Hirsch, A.M. Antifungal Activity of Bacillus Species against Fusarium and Analysis of the Potential Mechanisms Used in Biocontrol. Front. Microbiol. 2018, 9, 2363. [Google Scholar] [CrossRef]
- Kumari, S.; Khanna, V. Biological Management of Vascular Wilt of Chickpea (Cicer arietinum L.) Incited by Fusarium oxysporum f. sp. ciceris by Antagonistic Rhizobacteria Co-Inoculated with Native Mesorhizobium. Int. J. Curr. Microbiol. Appl. Sci. 2018, 7, 920–941. [Google Scholar] [CrossRef]
- Sharifi, R.; Kiani, H.; Ahmadzadeh, M.; Behboudi, K. Optimization of Acetoin Production by Biological Control Strain Bacillus Subtilis GB03 Using Statistical Experimental Design. J. Microb. Biol. 2019, 8, 47–57. [Google Scholar] [CrossRef]
- Balderas-Ruíz, K.A.; Bustos, P.; Santamaria, R.I.; González, V.; Cristiano-Fajardo, S.A.; Barrera-Ortíz, S.; Mezo-Villalobos, M.; Aranda-Ocampo, S.; Guevara-García, Á.A.; Galindo, E.; et al. Bacillus velezensis 83 a bacterial strain from mango phyllosphere, useful for biological control and plant growth promotion. AMB Express 2020, 10, 163. [Google Scholar] [CrossRef]
- Abdallah, M.; Benoliel, C.; Drider, D.; Dhulster, P.; Chihib, N.-E. Biofilm formation and persistence on abiotic surfaces in the context of food and medical environments. Arch. Microbiol. 2014, 196, 453–472. [Google Scholar] [CrossRef]
- Lee, J.H.; Lee, J. Indole as an Intercellular Signal in Microbial Communities. FEMS Microbiol. Rev. 2010, 34, 426–444. [Google Scholar] [CrossRef] [PubMed]
- Fernández-Llamosas, H.; Díaz, E.; Carmona, M. Motility, Adhesion and c-di-GMP Influence the Endophytic Colonization of Rice by Azoarcus sp. CIB. Microorganisms 2021, 9, 554. [Google Scholar] [CrossRef] [PubMed]
- Goswami, D.; Thakker, J.N.; Dhandhukia, P.C. Portraying mechanics of plant growth promoting rhizobacteria (PGPR): A review. Cogent Food Agric. 2016, 2, 1127500. [Google Scholar] [CrossRef]

| Phyllobacterial Isolates | Source Plant Parts | Host Plants (Common Name) | Host Plants (Botanical Name) | Family |
|---|---|---|---|---|
| S-3 | Stem | Cucumber | Cucumis sativus | Cucurbitaceae |
| S-4 | Stem | Bottle Gourd | Lagenaria siceraria | Cucurbitaceae |
| GL-9 | Leaf | Bottle Gourd | Lagenaria siceraria | Cucurbitaceae |
| GL-10 | Leaf | Bottle Gourd | Lagenaria siceraria | Cucurbitaceae |
| SG-6 | Leaf | Sweat Gourd | Cucurbita pepo | Cucurbitaceae |
| SG-7 | Leaf | Sweat Gourd | Cucurbita pepo | Cucurbitaceae |
| L-1 | Leaf | Cucumber | Cucumis sativus | Cucurbitaceae |
| L-2 | Leaf | Cucumber | Cucumis sativus | Cucurbitaceae |
| L-3 | Leaf | Cucumber | Cucumis sativus | Cucurbitaceae |
| L-4 | Leaf | Cucumber | Cucumis sativus | Cucurbitaceae |
| L-6 | Leaf | Bottle Gourd | Lagenaria siceraria | Cucurbitaceae |
| Bacterial Isolates | Colony Color | Colony Morphology | Shape | Citrate Test | Catalase Test | KOH Test | Gram Staining | Oxidase Test | Identification | Similarity |
|---|---|---|---|---|---|---|---|---|---|---|
| S-3 | Opaque | Smooth | Rod | + | + | − | +ve | + | Bacillus vallismortis | 100% |
| S-4 | Creamy white | Rough with irregular margins | Rod | + | + | − | +ve | + | B. velezensis | 99.40% |
| GL-9 | Creamy white | Rough | Rod | + | + | − | +ve | + | B. velezensis | 99.93% |
| GL-10 | Pale yellow | Wrinkled and rough surfaces | Rod | + | + | − | +ve | + | B. amyloliquefaciens | 99.83% |
| SG-6 | Creamy white | Rough with irregular margins | Rod | + | + | − | +ve | + | B. velezensis | 99.83% |
| SG-7 | Pale yellow | Wrinkled and rough surfaces | Rod | + | + | − | +ve | + | B. amyloliquefaciens | 99.00% |
| L-1 | Pale yellow | Wrinkled and rough surfaces | Rod | + | + | +ve | + | B. amyloliquefaciens | 99.50% | |
| L-2 | Creamy White | Rough with irregular margins | Rod | + | + | − | +ve | + | B. velezensis | 99.65% |
| L-3 | Slightly yellow | Rough | Rod | + | + | − | +ve | + | B. subtilis | 99.85% |
| L-4 | Creamy white | Rough with irregular margins | Rod | + | + | − | +ve | + | B. velezensis | 100% |
| L-6 | Slightly yellow | Rough | Rod | + | + | − | +ve | + | B. subtilis | 100% |
| Isolate | Motility | Biofilm Formation (OD600) | Phosphate Solubilization | Growth in N2-Free Medium | IAA Production (µg/mL) |
|---|---|---|---|---|---|
| S-3 | + | 0.17 ± 0.01 * | + | + | 35.32 ± 0.32 |
| S-4 | + | 0.19 ± 0.01 | + | + | 60.00 ± 0.41 |
| GL-9 | + | 0.20 ±0.01 | + | + | 33.55 ± 0.39 |
| GL-10 | + | 0.14 ± 0.01 | + | + | 55.00 ± 0.46 |
| SG-6 | + | 0.21 ± 0.01 | + | + | 56.44 ± 0.34 |
| SG-7 | + | 0.27 ± 0.02 | + | + | 40.22 ± 0.23 |
| L-1 | + | 0.13 ± 0.01 | + | + | 38.00 ± 0.40 |
| L-2 | + | 0.26 ± 0.02 | + | + | 10.44 ± 0.11 |
| L-3 | + | 0.21 ± 0.01 | + | + | 15.00 ± 0.14 |
| L-4 | + | 0.23 ± 0.03 | + | + | 40.00 ± 0.27 |
| L-6 | + | 0.18 ± 0.01 | + | + | 45.55 ± 0.38 |
| Isolate | Ammonia | Acetoin | Sidero-Phore | HCN | Indole | Chitinase | Protease | Lipase | Cellulase | Radial Growth of C. orbiculare (cm) | Growth Inhibition (%) of C. orbiculare |
|---|---|---|---|---|---|---|---|---|---|---|---|
| S-3 | + | + | + | + | + | + | + | + | + | 3.8 ± 0.02 d * | 94.44 ± 0.12 |
| S-4 | + | + | + | + | + | + | + | + | + | 4.0 ± 0.02 c | 88.88 ± 0.24 |
| GL-9 | + | + | + | + | + | + | + | + | + | 3.8 ± 0.01 d | 94.44 ± 0.04 |
| GL-10 | + | + | + | + | + | + | + | + | + | 3.8 ± 0.02 d | 94.44 ± 0.33 |
| SG-6 | + | + | + | + | + | + | + | + | + | 4.4 ± 0.01 b | 77.77 ± 0.31 |
| SG-7 | + | + | + | + | + | + | + | + | + | 4.0 ± 0.01 c | 88.88 ± 0.54 |
| L-1 | + | + | + | + | + | + | + | + | + | 4.4 ± 0.02 b | 77.77 ± 0.47 |
| L-2 | + | + | + | + | + | + | - | + | + | 3.8 ± 0.01 d | 94.44 ± 0.62 |
| L-3 | + | + | + | + | + | + | + | + | + | 4.2 ± 0.01 b | 83.33 ± 0.34 |
| L-4 | + | + | + | + | + | + | + | + | + | 3.9 ± 0.01 c | 91.66 ± 0.62 |
| L-6 | + | + | + | + | + | + | + | + | + | 3.8 ± 0.01 d | 94.44 ± 0.28 |
| Control | − | − | − | − | − | − | − | − | − | 7.2 ± 0.03 a | − |
Disclaimer/Publisher’s Note: The statements, opinions and data contained in all publications are solely those of the individual author(s) and contributor(s) and not of MDPI and/or the editor(s). MDPI and/or the editor(s) disclaim responsibility for any injury to people or property resulting from any ideas, methods, instructions or products referred to in the content. |
© 2025 by the authors. Licensee MDPI, Basel, Switzerland. This article is an open access article distributed under the terms and conditions of the Creative Commons Attribution (CC BY) license (https://creativecommons.org/licenses/by/4.0/).
Share and Cite
Nahar, M.H.K.; Briste, P.S.; Islam, M.R.; Anik, T.R.; Rubayet, M.T.; Khan, I.; Hossain, M.M.; Mostofa, M.G. Phyllosphere Antagonistic Bacteria Induce Growth Promotion and Effective Anthracnose Control in Cucumber. Appl. Microbiol. 2025, 5, 94. https://doi.org/10.3390/applmicrobiol5030094
Nahar MHK, Briste PS, Islam MR, Anik TR, Rubayet MT, Khan I, Hossain MM, Mostofa MG. Phyllosphere Antagonistic Bacteria Induce Growth Promotion and Effective Anthracnose Control in Cucumber. Applied Microbiology. 2025; 5(3):94. https://doi.org/10.3390/applmicrobiol5030094
Chicago/Turabian StyleNahar, Mst. Habiba Kamrun, Preangka Saha Briste, Md. Rabiul Islam, Touhidur Rahman Anik, Md. Tanbir Rubayet, Imran Khan, Md. Motaher Hossain, and Mohammad Golam Mostofa. 2025. "Phyllosphere Antagonistic Bacteria Induce Growth Promotion and Effective Anthracnose Control in Cucumber" Applied Microbiology 5, no. 3: 94. https://doi.org/10.3390/applmicrobiol5030094
APA StyleNahar, M. H. K., Briste, P. S., Islam, M. R., Anik, T. R., Rubayet, M. T., Khan, I., Hossain, M. M., & Mostofa, M. G. (2025). Phyllosphere Antagonistic Bacteria Induce Growth Promotion and Effective Anthracnose Control in Cucumber. Applied Microbiology, 5(3), 94. https://doi.org/10.3390/applmicrobiol5030094

